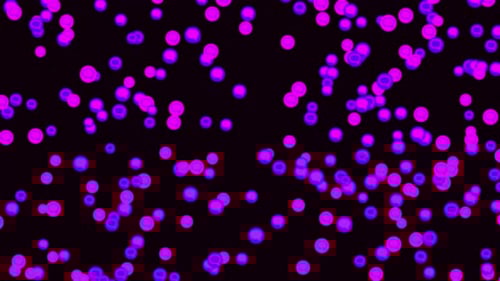
Bright purple and pink cloud of dialog circles

Fluid Cloud At Symbol Logo Reveal
By 02labAttributes
- Length
- 0:14
- Resolution
- 1920 x 1080
- File Size
- 55.7 MB
- Frame Rate
- 25 fps
- Alpha Channel
- Yes
- Looped
- No
- Video Encoding
- Photo JPEG
- Orientation
- Horizontal
- Commercial License
- Further Information
Description
This animated clip features a dynamic cloud formation that elegantly shapes into the iconic '@' symbol against a vibrant blue sky background. The ethereal, organic motion of the cloud creates a light and airy visual tone, ideal for introducing a brand or concept with a natural, yet digital-savvy feel. This visual effect can be used as a distinctive logo reveal, an opener for social media content, or to highlight internet and communication themes. The animation is provided with an alpha channel for easy integration into various projects.
Fluid Cloud At Symbol Logo Reveal by 02lab